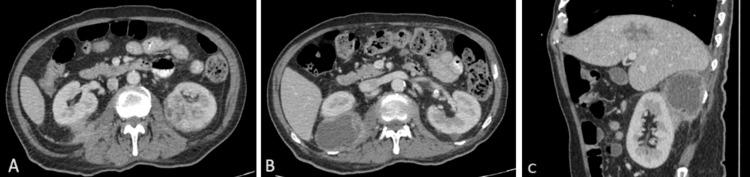

伴有多发性肝脓肿和肾脓肿的侵袭性克雷伯菌综合征
Invasive Klebsiella Syndrome With Multiple Liver and Renal Abscesses.
作者信息
Tan Pin Ru, Mohd Nasran Natasha, Chang Chee Yik
机构信息
Medical Education, Newcastle University Medicine Malaysia (NUMed), Johor Bahru, MYS.
Radiology, MARA University of Technology, Selangor, MYS.
出版信息
Cureus. 2025 May 13;17(5):e84052. doi: 10.7759/cureus.84052. eCollection 2025 May.
Invasive Klebsiella syndrome (IKS) is a significant health concern, particularly in Asia, as it results in a high mortality rate. Due to the hypervirulent strains of , it is more frequently detected among immunosuppressed individuals and will mainly metastasize to different organs, including the liver, kidneys, eyes, and brain. Here, we present the case of a 70-year-old man with underlying diabetes mellitus who developed multiple organ abscesses secondary to , requiring prolonged antibiotic treatment and abscess drainage. This case report highlights the importance of early diagnosis and appropriate antibiotic therapy to improve patient outcomes.
侵袭性克雷伯菌综合征(IKS)是一个重大的健康问题,尤其是在亚洲,因为它会导致高死亡率。由于其高毒力菌株,它在免疫抑制个体中更频繁地被检测到,并且主要会转移到不同器官,包括肝脏、肾脏、眼睛和大脑。在此,我们报告一例70岁患有基础糖尿病的男性患者,其因[未提及具体病因]继发多个器官脓肿,需要长期抗生素治疗和脓肿引流。本病例报告强调了早期诊断和适当抗生素治疗对改善患者预后的重要性。